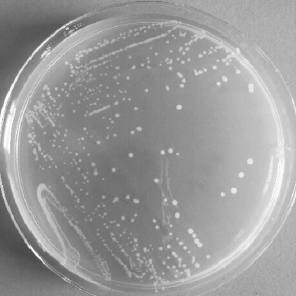

赛马知识
什么是马红球菌?
马红球菌属放线菌目、诺卡菌科、红球菌属。该菌是一种革兰阳性兼性胞内寄生菌,菌落为粉色或黄色,棒状或球形,耐酸,无孢子,大多无鞭毛,但有些菌株有菌毛或附肢。马红球菌的细胞壁具有疏水性且被多糖荚膜所围绕,其细胞壁的主要成分为富含霉菌酸(Mycolicacids)的脂质和脂多糖,其中脂多糖为海藻糖二甲酸酯(Trehalose dimycolate,TDM)和脂阿拉伯糖甘露聚糖(Lipoarabinomannans,LAM)。
LB固体培养基上马红球菌的菌落形态

马红球菌的透射电镜下的超微结构形态
马红球菌广泛存在于土壤中,同时也可以在草食动物粪便和大肠中繁殖,通过粪口途径在农场栖息地中传播。马红球菌感染又称幼驹传染性支气管肺。以1-6月龄幼驹发生化脓性支气管炎为特征。可经消化道和呼吸道感染。
病驹在发病初期:精神沉郁,食欲减退,时有咳嗽,随后出现稽留高温,结膜潮红,贫血。
随着病情的发展,发生化脓性肺炎,呼吸迫促,鼻腔流脓液性分泌物,以后转为脓性。有的病驹关节肿大,最后卧地不起,多因脓毒败血症而死。

马红球菌感染患者的革兰染色痰镜检查显示,大量白细胞含有多形性革兰阳性球菌
编辑:陈晓敏
核发: 陈晓敏


上一篇: